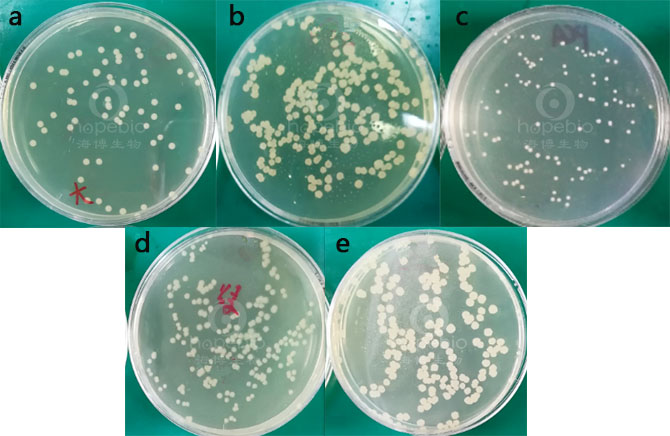
产品细节图片1

万千商家帮你免费找货
0 人在求购买到急需产品
- 详细信息
- 询价记录
- 文献和实验
- 技术资料
- 保存条件:
请置于阴凉避光处保存
- 保质期:
3年
- 英文名:
Plate Count Agar
- 库存:
100
- 供应商:
青岛海博生物
- 规格:
250g
用途:用于菌落总数的测定。
成分(g/L)
| 胰蛋白胨 | 5.0 |
| 酵母浸粉 | 2.5 |
| 葡萄糖 | 1.0 |
| 琼脂 | 15.0 |
| pH值7.0±0.2 | 25℃ |
检验原理:
胰蛋白胨提供碳源和氮源;酵母浸粉提供B 族维生素;葡萄糖提供能源;琼脂是培养基的凝固剂。
用法:
称取本品23.5g,加热溶解于1000ml蒸馏水中,分装三角瓶,121℃高压灭菌15分钟,备用。
平板计数琼脂(PCA)微生物质控结果:
a:大肠埃希氏菌;b:枯草芽孢杆菌;c:金黄se葡萄球菌;d:铜绿假单胞菌;e:蜡样芽孢杆菌
平板计数琼脂(PCA)微生物灵敏度试验:
按标签用法制备培养基,接种以下质控菌株,放置36±1℃需氧培养48±2小时。


风险提示:丁香通仅作为第三方平台,为商家信息发布提供平台空间。用户咨询产品时请注意保护个人信息及财产安全,合理判断,谨慎选购商品,商家和用户对交易行为负责。对于医疗器械类产品,请先查证核实企业经营资质和医疗器械产品注册证情况。
- 作者
- 内容
- 询问日期
文献和实验一、培养基和试剂平板计数琼脂、75%乙醇、磷酸盐缓冲稀释液二、操作程序1.样品制备(1)以无菌操作取有代表性的样品盛于灭菌容器内。如有包装,则用75%乙醇在包装开口处擦拭后取样。(2)制备样品匀液:以无菌操作取25g样品,放入装有225ml稀释剂的灭菌均质杯内,于8000r/min均质1-2min,制成1:10的样品匀液。如样品均质时间超过2min,应在均质杯外加冰水冷却。(3)稀释样品匀液:用10ml灭菌吸管准确吸取1:10的样品匀液10ml,放入装有90ml稀释剂的150ml 稀释瓶中
1 主题内容与适用范围本文规定了食品平板菌落计数的方法。本文适用于航空配餐的各种半成品、成品及原料,有专门规定的检验方法的除外。2 设备和材料超净工作台、恒温培养箱(36±1℃)、均质器、振荡器、吸管(1ml、10ml)、平皿、稀释瓶、天平等3 培养基和试剂平板计数琼脂、75%乙醇、磷酸盐缓冲稀释液4 操作程序4.1 样品制备4.1.1 以无菌操作取有代表性的样品盛于灭菌容器内。如有包装,则用75%乙醇在包装开口处擦拭后取样。4.1.2 制备样品匀液以无菌操作取25g样品,放入装有225ml
一、基本原理培养基的种类很多,不同微生物所需要的培养基不同。培养基制成后的物理状态可分为液体、固体、半固体三种类型。目前所用培养基均为已配制好的生物试剂和纸片。二、器材三角瓶、试管、烧杯、玻棒、天平、搪瓷杯、量筒、铝箔纸、角匙、杜氏小管、硅胶塞、电炉三、培养基的种类营养琼脂培养基、乳糖胆盐发酵培养基、乳糖发酵培养基、伊红美兰琼脂培养基、马铃薯-葡萄糖琼脂培养基(附加抗菌素)、平板计数琼脂、月桂基硫酸盐胰蛋白冻肉汤、煌绿乳糖胆盐肉汤、EC肉汤、高盐察氏琼脂、三糖铁琼脂等四、方法步骤1、培养
技术资料暂无技术资料 索取技术资料











